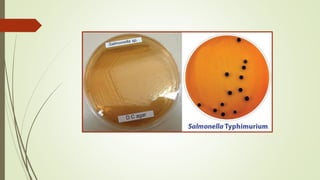
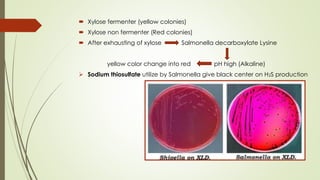
 Xylose fermenter (yellow colonies)
 Xylose non fermenter (Red colonies)
 After exhausting of xylose Salmonella decarboxylate Lysine
yellow color change into red pH high (Alkaline)
➢ Sodium thiosulfate utilize by Salmonella give black center on H2S production

The document discusses the isolation and identification of Salmonella species, particularly focusing on their classification, historical aspect, virulence factors, and methods for sampling and identification. It highlights the importance of Salmonella enterica in causing human infections, both non-typhoidal and typhoidal, as well as the various serotypes and their effects on animals. Additionally, it covers diagnostic tests including biochemical and serological methods to detect Salmonella and outlines the implications of multi-drug resistance in food sources.